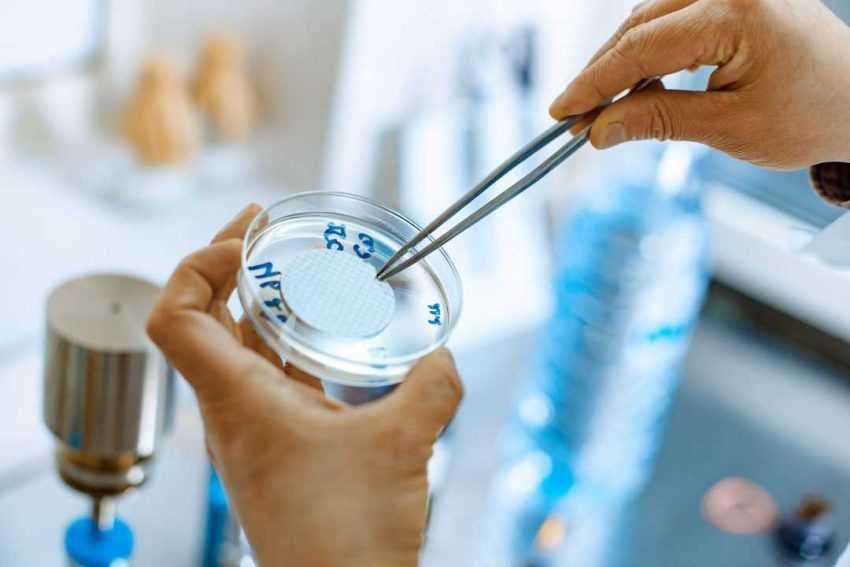

Analizele efectuate recent de S.C. Edilul CGA S.A. arată că apa potabilă provenită de la Stația de Tratare Calea Pietroasă, precum și cea utilizată la Școala Gimnazială comuna Bughea de Jos și în comuna Bughea de Jos-rezervor Mlăci confirmă că apa potabilă furnizată de S.C. Edilul CGA S.A. respectă toate normele legale în vigoare privind calitatea apei destinate consumului uman. Rezultatele arată că atât parametrii fizico-chimici, cât și cei microbiologici se încadrează în limitele admise, conform Ordonanței nr. 7/2023 și Legii nr. 96/2024.
Iată care sunt rezultatele analizelor la plecarea din Staţia de Tratare Calea Pietroasă şi din cele două puncte ale reţelei de distribuţie de unde au fost prelevate probe:
1.Tip probă: apă potabilă
Client: S.C. EDILUL CGA S.A.
Loc de prelevare: Plecare Staţia de Tratare Calea Pietroasă
Data executării: 21.10.2025
Proba prelevată conform SR ISO 5667-5/2017 şi ISO 19458/2007 (E)
Observaţii:
- apa se încadrează în valorile admise, conform Ordonanței nr.7/18.01.2023 privind calitatea apei destinate consumului uman, aprobată prin Legea nr. 96/2024
- pH: (valoare admisă: 6,5-9,5 unităţi de pH), valoare obţinută: 7,4
- Turbiditate: (valoare admisă: acceptabilă), valoare obţinută: 1,04 FNU
- Amoniu (NH4+): (valoare admisă: 0,50 mg/l), valoare obţinută: ˂0,03 mg/l
- Azotaţi (NO3–) (valoare admisă: 50 mg/l), valoare obţinută: 0,80 mg/l
- Azotiţi (NO2–) (valoare admisă: 0,50 mg/l), valoare obţinută: ˂0,01mg/l
- Clor rezidual (Cl2) liber (valoare admisă: 0,1-0,5 mg/l), valoare obţinută: 0,50 mg/l
- Duritate totală (valoare admisă: >5 grade germane), valoare obţinută: 1,94
- Din punct de vedere microbiologic, apa este conformă.
2. Tip probă: apă potabilă
Client: S.C. EDILUL CGA S.A.
Data executării: 21.10.2025
Proba prelevată conform SR ISO 5667-5/2017 şi ISO 19458/2007 (E)
Observaţii:
- apa se încadrează în valorile admise, conform Ordonanței nr.7/18.01.2023, aprobată prin Legea nr. 96/2024
- pH: (valoare admisă: 6,5-9,5 unităţi de pH), valoare obţinută: 6,7
- Turbiditate: (valoare admisă: acceptabilă), valoare obţinută: 0,58 FNU
- Amoniu (NH4+): (valoare admisă: 0,50 mg/l), valoare obţinută: ˂0,03 mg/l
- Azotaţi (NO3–) (valoare admisă: 50 mg/l), valoare obţinută: 3,80 mg/l
- Azotiţi (NO2–) (valoare admisă: 0,50 mg/l), valoare obţinută: ˂0,01 mg/l
- Clor rezidual (Cl2) liber (valoare admisă: 0,1-0,5 mg/l), valoare obţinută: 0,10 mg/l
- Duritate totală (valoare admisă: >5 grade germane), valoare obţinută: 2,24
- Din punct de vedere microbiologic, apa este conformă.
3.Tip probă: apă potabilă
Client: S.C. EDILUL CGA S.A.
Data executării: 21.10.2025
Proba prelevată conform SR ISO 5667-5/2017 şi ISO 19458/2007 (E)
Observaţii:
- apa se încadrează în valorile admise, conform Ordonanței nr.7/18.01.2023, aprobată prin Legea nr. 96/2024
- pH: (valoare admisă: 6,5-9,5 unităţi de pH), valoare obţinută: 6,9
- Turbiditate: (valoare admisă: acceptabilă), valoare obţinută: 0,54 FNU
- Amoniu (NH4+): (valoare admisă: 0,50 mg/l), valoare obţinută: ˂0,03 mg/l
- Azotaţi (NO3–) (valoare admisă: 50 mg/l), valoare obţinută: 3,80 mg/l
- Azotiţi (NO2–) (valoare admisă: 0,50 mg/l), valoare obţinută: ˂0,01 mg/l
- Clor rezidual (Cl2) liber (valoare admisă: 0,1-0,5 mg/l), valoare obţinută: 0,15 mg/l
- Duritate totală (valoare admisă: >5 grade germane), valoare obţinută: 3,80
- Din punct de vedere microbiologic, apa este conformă.
Foto descriptiv/ arhivă
Citiți, de asemenea, pe anchetaonline.ro